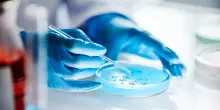
Sindrome Wiskott-Aldrich, terapia genica Telethon approvata in Usa

s

Cronaca
Via libera della Fda per la terapia genica di Telethon contro la sindrome di Wiskott-Aldrich
Oggi 10-12-25, 20:31
É la prima volta che un ente no profit viene autorizzato a distribuire negli Stati Uniti una terapia frutto della propria attività di ricerca e sviluppo
CONTINUA A LEGGERE

0

0

0
Guarda anche
La Repubblica
21:19
Trump: “Abbiamo sequestrato una petroliera al largo delle coste venezuelane”
La Repubblica
21:07
I love vivere, la lezione d’amore di Sophie Kinsella
La Repubblica
20:40